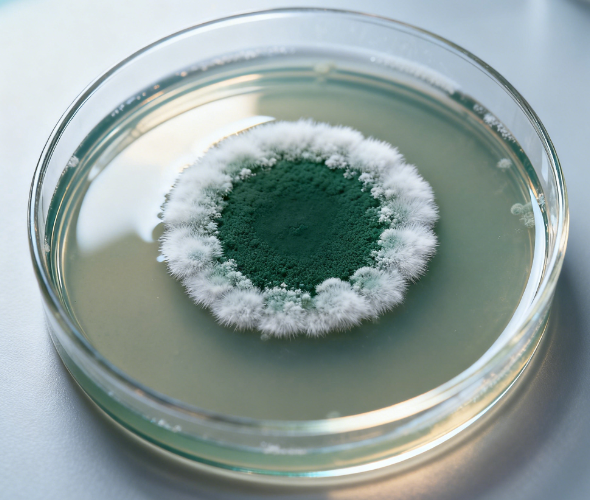
熒光定量檢測技術:免疫層析法如何實現精準定量?

萊恩德-儀器生產廠家專注于土壤和食品安全檢測技術的研發與應用
- 農業檢測儀器
- 食品安全儀器
- 水質檢測儀器
- 實驗室儀器
- 植物生理儀器
- 其他專用儀器
- 材料分析儀器
- 光譜分析儀器
- 石化分析儀器
- 疾控衛生儀器
- 糧油檢測儀器
- 分子生物儀器
智能微電腦測汞儀
LD-CG2
全自動顆粒強度測定儀
LD-KD4
手持式超聲波細胞破碎儀
LD-SCP300
火焰原子吸收光譜儀
LD-AAS1
熒光定量真菌毒素檢測儀
LD-LZ1
接觸角測量儀
LD-JC1
藥物殘留檢測儀器
LD-SY03
智能農藥殘留檢測儀
LD-NK14
萊恩德智能科技以先進科技守護土壤與食品的純凈安全
查看更多
山東萊恩德智能科技有限公司,作為一家深耕于快速檢測儀器領域的高新技術企業,致力于研發、銷售及提供卓越的售后服務。公司在土壤、食品與水質檢測儀三大核心板塊上,展現出了顯著的專業實力與深厚的技術積累,擁有多元化且高質量的產品系列。在土壤檢測儀、食品檢測儀以及水質檢…



我們的核心優勢推動行業發展,只為帶給您更好檢測儀器

- 生態農業
- 食品安全
- 健康水質
- 智能實驗室
- 植物生理
多年智能儀器設備制造經驗
始終如一集研發、設計、生產、銷售土壤養分檢測儀、土壤研磨機、多功能食品安全檢測儀等產品為一體,自有專業研發、生產、銷售團隊。
所有儀器設備均源頭廠家直供
廠家直營,砍掉冗余供應鏈,扁平化供應,公司擁有嚴格的產品檢驗標準,從源頭把控儀器質量,原材到成品均由自己生產,產品均獲得正規產品檢測報告。
消費者信賴,與多家企業建立長期合作關系
所生產分析儀器設備在客戶中享有較高的口碑及地位,上百個產品系列,百種產品滿足不同用戶的需求,終身免費提供技術支持。
售后體系完善,為您全程服務
以超越客戶期望為目標,以誠信經營為準則,我們建立了售前、售中、售后一站式完整的服務體系,配備了專業的服務團隊,快速解決客戶的疑難點。
international market
國際市場,業務遍布全球
全球化的業務網絡
豐富的國際經驗
先進的技術與創新
強大的供應鏈管理
閱讀新聞資訊與您一起深入探討智能檢測儀器的創新
查看更多

萊恩德高精度土壤重金屬檢測儀:便攜式設計,滿足多場景檢測需求
國內/國外十大土壤團粒結構分析儀品牌推薦
熒光定量檢測技術:免疫層析法如何實現精準定量?
- 2025-11-24
精準測土不花冤枉錢!萊恩德土壤酸堿度檢測儀價格與實用性解析
- 2025-11-21
萊恩德LD-S水產品抗生素檢測儀 破解水產品抗生素快速檢測難題

在線咨詢
在線咨詢 微信
微信 一鍵電話
一鍵電話